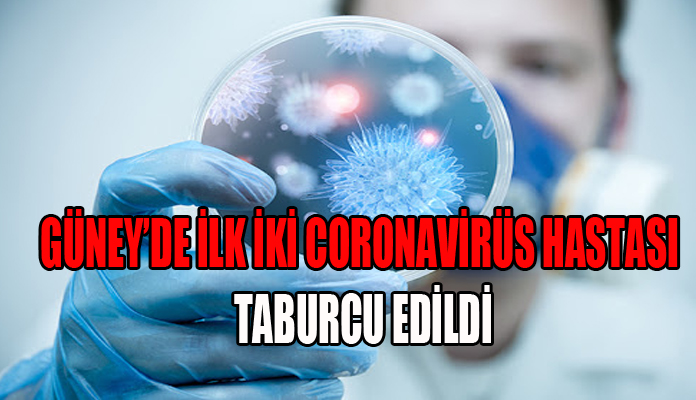

Güney KıbrısKıbrısManşet
Güney’de ilk iki coronavirüs hastası taburcu edildi
Kıbrıs Haber Ajansı’na göre, coronavirus pozitif test ettikten sonra tedavi için hastaneye kaldırılan ilk iki hasta bugün, virüsün sevk hastanesi Paralimni’deki Mağusa Hastanesi’nden taburcu edildi.
Taburcu olacak olan iki hasta, 14 gün boyunca kendi kendilerini tecrit edecekleri hükümet tarafından belirlenen tesislere transfer edilecek…





































